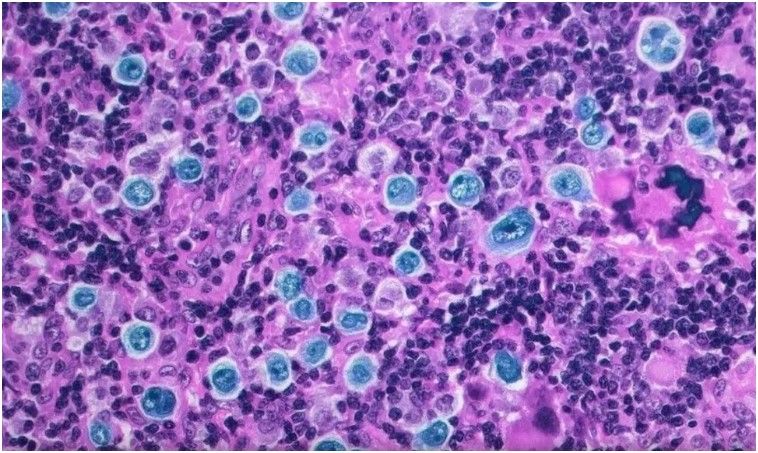
324172_1765720288.jpg

Grave siniestro vial en el Parque de la Ciudad: tres personas heridas tras una colisión entre motocicletas
Sociedad
Estudiaron en 15 centros médicos de ese país un nuevo protocolo para el linfoma de Hodgkin. El 95% de los pacientes lograron una remisión total de la enfermedad
Domingo 14 de Diciembre de 2025
10:14 | Domingo 14 de Diciembre de 2025 | La Rioja, Argentina | Fenix Multiplataforma
Los linfomas son los cánceres del sistema linfático, que afectan a una de cada 5.000 personas. En general, tienen altas chances de curación si son detectados a tiempo. Ahora, un equipo de investigadores en Israel logró un avance significativo: la remisión completa en pacientes con un estadio avanzado.
La investigación se centró particularmente en el linfoma de Hodgkin, que es menos frecuente que los linfomas de no Hodgkin. La diferencia entre ambos es el tipo de linfocito --una parte clave del sistema inmune-- involucrado. El linfoma de Hodgkin afecta más a adultos jóvenes y se presenta principalmente en la parte superior del cuerpo, como las axilas, el cuello o el pecho.
En los pacientes con linfoma de Hodgkin avanzado, el tratamiento tradicionalmente utilizado es la quimioterapia. Pero con los desarrollos de nuevas drogas, aparecieron las llamadas terapias dirigidas, mucho más específicas y con menos efectos adversos.
El equipo del Ichilov Medical Center de Tel Aviv evaluó justamente los resultados de estas terapias, un tratamiento que se llama BrECADD, sigla formada por la combinación de los nombres de las seis drogas que se utilizan. Este protocolo combina quimioterapias avanzadas con anticuerpos monoclonales conjugados con el agente quimioterápico, para llegar directamente a las células a atacar sin dañar el resto.
El análisis lo presentaron esta semana en el congreso de la Sociedad Americana de Hematología, el evento más relevante de la especialidad a nivel mundial. Los especialistas israelíes utilizaron lo que se llama "evidencia del mundo real", esto es, datos recopilados de los pacientes que recibieron el tratamiento en 15 centros de salud de Israel. Siguieron por dos años a 79 personas, de las cuales el 83% fueron diagnosticadas en un estadio IV, el más avanzado.
 Los especialistas que presentaron el estudio en un congreso en Estados Unidos. Foto Instagram @afshineemrani
Los especialistas que presentaron el estudio en un congreso en Estados Unidos. Foto Instagram @afshineemrani
El resultado fue sorprendente hasta para los propios investigadores: la tasa de supervivencia a un año fue del 100% y el 95% de los pacientes mostraron una remisión total, muy por encima de lo que se había visto en los ensayos clínicos.
Otros datos relevantes fueron que la "respuesta metabólica completa", esto es la remisión total, se vio en la mayoría de los pacientes con solo dos ciclos de tratamiento, es decir, en apenas nueve semanas. Y además, sólo el 4% de los pacientes necesitaron radioterapia, otro punto significativo por la reducción de los efectos tóxicos.
"Este nuevo protocolo de tratamiento representa una verdadera revolución en la atención del linfoma de Hodgkin. Les permite a los pacientes tener un control completo de la enfermedad y en algunos casos incluso una cura en sólo nueve semanas. En la mayoría de los pacientes, los signos del cáncer desaparecieron tempranamente en el proceso, y para el final del tratamiento había poca o nula evidencia de la enfermedad", dijo a medios israelíes Tzofia Levy, hematóloga del Rambam Health Care Campus de Haifa y una de las participantes del estudio.
Roy Vitkon es otro de los especialistas que participó. Hematólogo y médico internista en el Ichilov Medical Center, el año pasado leyó en The Lancet sobre un estudio alemán que introducía un tratamiento de primera línea en estos linfomas avanzados. Los resultados eran prometedores, por eso para el especialista es muy importante haber confirmado esto mismo en el mundo real.
"Somos los primeros en publicar datos del mundo real sobre este protocolo. La habilidad de alcanzar esta colaboración entre tantos centros es remarcable en sí mismo, y los resultados fueron excepcionales", señaló.
DEJANOS TU COMENTARIO
1 COMENTARIOS
ROSENFELD MARCOS
| Domingo 14 de Diciembre de 2025
Israel sigue beneficiando a la humanidad mientras el mundo "civilizado" sigue dándole la espalda y alentando a los terroristas, el mundo como siempre, patas arriba
Las Más Vistas

Grave siniestro vial en el Parque de la Ciudad: tres personas heridas tras una colisión entre motocicletas

Secuestraron en San Luis una camioneta denunciada en La Rioja por presunta estafa

Nueva encuesta y polémica: midieron un balotaje Milei vs. Kicillof para 2027 y a “Karina 2031”

Interceptaron casi 11 kilos de marihuana en un colectivo que iba a La Rioja

Grave siniestro vial: un motociclista fue trasladado al hospital tras chocar con una camioneta estacionada
Top Semanal
TAMBIÉN TE PUEDE INTERESAR
LOCALES
NACIONALES
INTERNACIONES
DEPORTES
SOCIEDAD
FARÁNDULA